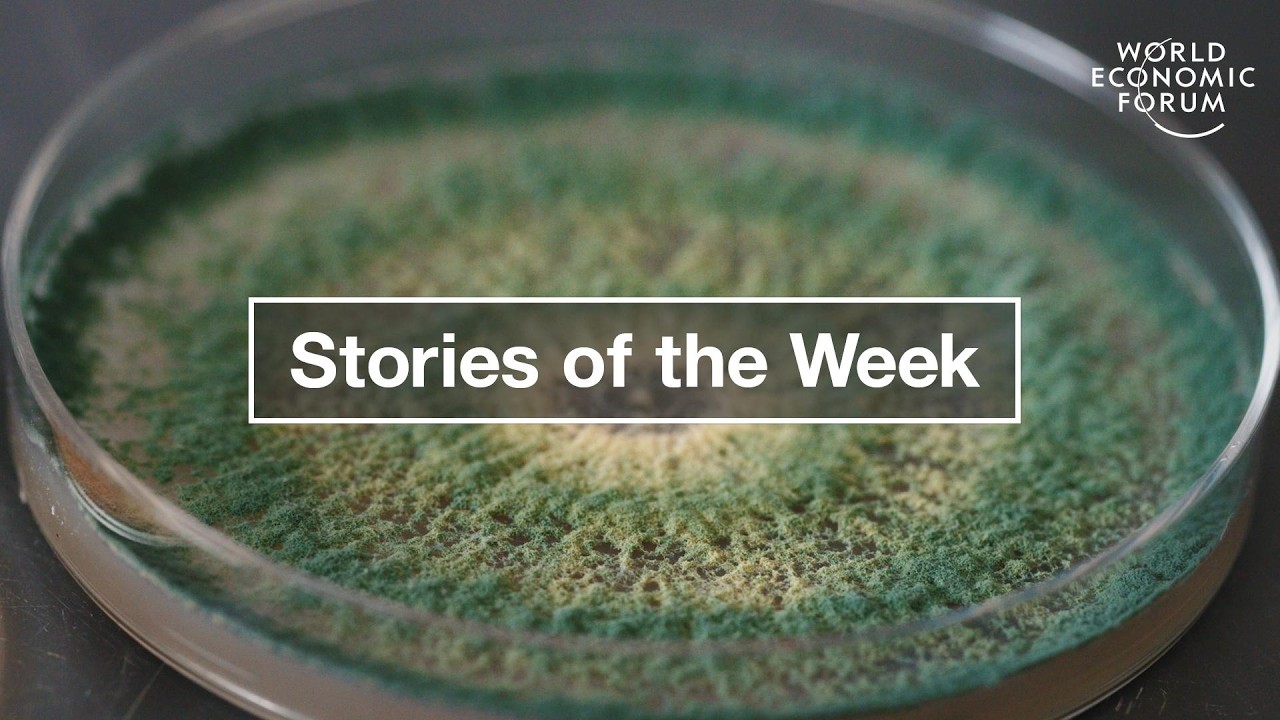
India's Growth Strategy & How AI Could Transform Work by 2030 | WEF | Top Stories of the Week

From RCA to Autonomous Ops: The Future of AI in Observability | Big Tent S3E7 скачать в хорошем качестве
Grafana
Monitoring
logs
dashboards
observability
dashboard
metrics
traces
visualization
Grafana Loki
Grafana Mimir
Grafana OnCall
Grafana Tempo
Graphite
Grafana K6
OpenTelemetry
Prometheus
OSS
Open Source
Pyroscope
logging
LGTM stack
Grafana Cloud
SLO
Performance Testing
Frontend observability
Profiling
Alerting
Grafana Beyla
Grafana Agent
OTel
Повторяем попытку...

Скачать видео с ютуб по ссылке или смотреть без блокировок на сайте: From RCA to Autonomous Ops: The Future of AI in Observability | Big Tent S3E7 в качестве 4k
У нас вы можете посмотреть бесплатно From RCA to Autonomous Ops: The Future of AI in Observability | Big Tent S3E7 или скачать в максимальном доступном качестве, видео которое было загружено на ютуб. Для загрузки выберите вариант из формы ниже:
-
Информация по загрузке:
Скачать mp3 с ютуба отдельным файлом. Бесплатный рингтон From RCA to Autonomous Ops: The Future of AI in Observability | Big Tent S3E7 в формате MP3:
Если кнопки скачивания не
загрузились
НАЖМИТЕ ЗДЕСЬ или обновите страницу
Если возникают проблемы со скачиванием видео, пожалуйста напишите в поддержку по адресу внизу
страницы.
Спасибо за использование сервиса ClipSaver.ru
From RCA to Autonomous Ops: The Future of AI in Observability | Big Tent S3E7
SREs are famously skeptical of AI — so how do you convince them to trust agents in production? In this episode of Grafana’s Big Tent, Tom Wilkie talks with Spiros Xanthos (Resolve AI), Manoj Acharya (Grafana Labs), and Cyril Tovena (Grafana Assistant team) about agent-first observability. They unpack knowledge graphs, LLM reasoning, autonomous debugging, pricing models, and the “Claude Code moment” for observability. Is autonomous production ops closer than we think? Timestamps: 03:00 – What is Resolve AI? 07:30 – Is agentic AI replacing engineers? 8:21 – Knowledge graphs before LLMs 20:00 – Context graphs in the era of AI agents 17:58 – AI skepticism, trust, and why AIOps struggled 25:02 – When will AI fully run production? 32:23 – Real-world RCA: the latent deadlock bug Resolve found 42:14 – AI increases query volume — what happens to pricing? Links/resources: Learn more about Grafana's Big Tent: https://bigtent.fm/ Get started with the Grafana Cloud forever-free tier: https://grafana.com/g/cloud Have a question? Ask Grot, your AI helper: https://grafana.com/grot/ Reach out in our community forums: https://gra.fan/communityyf --- Thanks for watching! 👍 Was this video helpful? Like and subscribe to our channel for more videos. Connect with Grafana Labs: X: ( / grafana ) LinkedIn: ( / grafana-labs ) Facebook: ( / grafana ) #Grafana #Observability